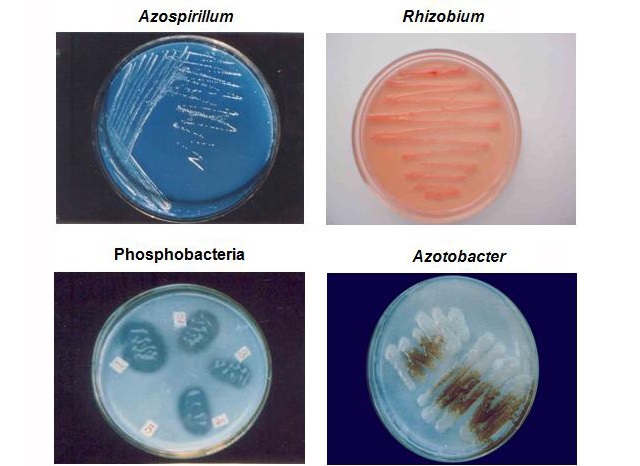
Một số vi sinh vật có lợi cho đất và cây trồng

Tin tức, Trồng Trọt
Vai trò của vi sinh vật đối với đất trồng trong canh tác nông nghiệp
Nếu để trả lời đâu là nguồn dinh dưỡng thiết yếu đối với các loại cây trồng hiện nay thì đó chắc chắn phải là vi sinh vật. Đây là những sinh vật nhỏ bé mà bằng mắt thường chúng ta không thể nhìn thấy được. Chúng sống trong đất và đóng vai trò quan trọng trong sự phát triển của cây trồng. Vậy chính xác vi sinh vật có vai trò gì và làm thế nào để tạo ra chúng một cách hiệu quả, an toàn? Hãy cùng Chế phẩm vi sinh Đức Bình khám phá trong bài viết: Vai trò của vi sinh vật đối với đất trồng trong canh tác nông nghiệp

1. Vi sinh vật đất là gì?
Vi sinh vật là thành phần chiếm đại đa số trong đất và đóng một vai trò hết sức quan trọng. Theo như nghiên cứu thì số lượng vi sinh vật có trong đất nhiều hơn cả về thành phần cũng như số lượng nếu để so với các môi trường khác. Lý do là vì trong các loại đất của chúng ta có chứa hàm lượng chất hữu cơ rất cao mà đây lại là nguồn thức ăn chính của nhóm sinh vật này. Chính vì thế mà đất trở thành nơi cư trú rộng rãi của vi sinh vật.
Hệ vi sinh vật đất bao gồm nhiều nhóm khác nhau với những đặc tính hình thái, sinh lý cũng như sinh hoá rất khác nhau. Có thể kể đến các nhóm vi sinh vật chính tồn tại trong đất bao gồm: Vi khuẩn, Vi nấm, Virus, Tảo, Xạ khuẩn, Nguyên sinh động vật. Nhóm chiếm số lượng nhiều nhất đó chính là vi khuẩn với những cái tên như: vi khuẩn kị khí, vi khuẩn háo khí, vi khuẩn tự dưỡng, vi khuẩn dị dưỡng,…
2. Thực trạng đất cạn kiệt vi sinh vật
Có một thực tế hiện nay đó là hệ vi sinh vật tự nhiên trong đất đang ngày càng suy giảm và cạn kiệt dần. Minh chứng đó là đất trồng ngày càng giảm dần khả năng hấp thụ cũng như khó có thể tự thực hiện chuyển hóa các chất được bón vào. Điều này dẫn đến những tình trạng như: đất bạc hóa, mất khả năng giữ nước, không còn đảm bảo độ tơi xốp đồng thời độ pH trong đất bị mất cân bằng.
Cứ như vậy, ngày qua ngày, môi trường đất dần bị thoái hóa khiến cho mật độ vi sinh vật có trong đất ngày càng trở nên thưa thớt hơn. Bên cạnh đó, dưới sự tác động của thuốc và phân bón hóa học khi chúng được sử dụng bừa bãi, thiếu trách nhiệm lại càng khiến cho quần thể vi sinh vật đất bị mất cân bằng và bị tiêu diệt hàng loạt. Nếu như chúng ta không thay đổi thói quen sản xuất nông nghiệp cũng như có phương án cải tạo đất, tạo điều kiện để vi sinh vật phát triển thì chắc chắn sẽ phải gánh chịu những điều không tưởng từ thiên nhiên.

3. Một số vi sinh vật trong đất có lợi
Để giúp cho người nông dân có thể hiểu được vai trò của vi sinh vật có lợi trong đất trong quá trình trồng trọt, trước hết, chúng ta cần nắm biết được có những loại vi sinh vật phổ biến nào hiện nay có lợi đối với đất và cây trồng nhất.
3.1 Vi sinh vật cố định đạm
Vi sinh vật cố định đạm (Nitơ) có vai trò chính đó là giúp cố định thành phần Nitơ (N2) trong đất và cây trồng. Như chúng ta cũng đã biết thì đạm (Nitơ – N) chính là một trong những nguồn dinh dưỡng vô cùng quan trọng và thiết yếu cho sự phát triển của cây trồng.
Nhưng các loại cây trồng chỉ có thể hấp thụ được chất đạm ở dạng NH4+ hay NO3– mà thôi. Và để hỗ trợ cho quá trình chuyển hoá Nitơ trong tự nhiên thành những chất dinh dưỡng mà cây có thể hấp thụ được thì lúc này lại cần đến vai trò của vi sinh vật. Đặc biệt, nhóm vi sinh vật Rhizobium sống cộng sinh ở rễ cây họ đậu có khả năng chuyển hóa $N_2$ không khí thành đạm cây hấp thụ trực tiếp.
⫸ Xem thêm: Phân vi sinh cố định đạm: Phân loại, công dụng và cách sử dụng
3.2 Vi sinh vật phân giải lân
Tác dụng chính của Lân (Photpho – P) đó là kích thích bộ rễ có thể phát triển đồng thời thúc đẩy quá trình làm chín quả. Như vậy, chúng ảnh hưởng trực tiếp đến sản lượng cũng như chất lượng nông sản.
Nhưng cũng tương tự như N, cây trồng của chúng ta chỉ có thể hấp thu được Lân sau khi đã được vi sinh vật thực hiện phân giải. Các loại vi sinh vật chính đóng góp cho quá trình phân giải hỗ trợ cây hấp thu được Lân đó là: vi khuẩn, xạ khuẩn (Pseudomonas, Alcaligenes,…) và một số loại nấm (Penicillium, Aspergillus,…). Chúng sẽ tiến hành tiết ra acid hữu cơ với độ pH phù hợp. Từ đó, chuyển hóa Lân khó tan thành chất dinh dưỡng cần thiết cho quá trình nuôi cây.
⫸ Xem thêm: Phân bón vi sinh chuyển hoá lân là gì?
3.3 Vi sinh vật phân giải Kali
Nhu cầu hấp thụ Kali của cây là rất nhiều vì chúng ảnh hưởng trực tiếp đến quá trình trao đổi chất của cây. Đồng thời, tăng khả năng giữ nước cũng như chống chịu lại các loại sâu, bệnh hại đến cây trồng. Từ đó, tăng cường sức đề kháng cho cây để chống lại những tác động đến từ thời tiết và môi trường.
Các loại vi sinh vật giúp phân giải Kali đó là: Bacillus mucilaginosus hoặc nấm Aspergillus. Không chỉ giúp cho cây trồng hấp thụ Kali mà chúng còn bổ sung thêm một số dưỡng chất cần thiết khác đó là: sắt, mangan,…

⫸ Xem thêm: Kali hữu cơ là gì? Công dụng và cách làm Kali hữu cơ bón cây
3.4 Vi sinh vật kích thích tăng trưởng
Nhóm vi sinh vật cũng rất quan trọng được sử dụng với mục đích kích thích sự tăng trưởng của cây bao gồm có: Pseudomonas, Azospirillum, Bacillus, Enterobacter… Chúng hoạt động theo cơ chế đó là tiết ra các chất có lợi cho cây như phytohormone (hormone thực vật) và các axit amin. Tạo điều kiện để cây hấp thụ các chất dinh dưỡng một cách nhanh chóng và hiệu quả hơn. Bên cạnh đó, chúng cũng giúp ngăn ngừa các tác nhân gây bệnh cho cây để giúp cây tăng đề kháng và phát triển tốt hơn.
3.5 Vi sinh vật phân giải Cellulose
Vi sinh vật phân giải Cellulose được chia thành 2 nhóm chính đó là: hiếu khí và kị khí. Đặc điểm của các loại vi sinh vật này đó là có hoạt tính sinh học cao nên cực kỳ tốt cho đất cũng như cây trồng. Nếu như bạn quan tâm tìm hiểu sâu về nông nghiệp thì chắc chắn sẽ biết đây là loại vi sinh vật được dùng để sản xuất ra chế phẩm vi sinh vật có khả năng phân giải Cellulose.
Công dụng của chế phẩm vi sinh vật có khả năng phân giải Cellulose đó là:
- Giúp đẩy nhanh quá trình phân giải các phế phẩm nông nghiệp (như rơm rạ, vỏ cà phê, bã trà) được người trồng sử dụng cho cây tạo thành phân hữu cơ vi sinh. Từ đó, cây trồng của chúng ta có thể hấp thụ một cách dễ dàng hơn.
- Thúc đẩy quá trình mùn hóa của đất giúp đất tơi xốp và nhiều dinh dưỡng hơn.
- Tạo kháng sinh tự nhiên cho cây từ đó ngăn ngừa các loại vi sinh vật có hại gây bệnh cho cây.
- Giảm mầm bệnh cũng như khử mùi hôi có trong rác thải.

3.6 Vi sinh vật đối kháng và kiểm soát dịch bệnh
Ngoài vai trò cung cấp và chuyển hóa dinh dưỡng, nhóm vi sinh vật đối kháng (như Trichoderma, Bacillus) còn đóng vai trò như một “lực lượng bảo vệ” tự nhiên cho cây trồng. Các vi sinh vật này cạnh tranh thức ăn và không gian sống với các tác nhân gây bệnh (nấm, vi khuẩn gây hại) trong đất.
- Tác động đối kháng trực tiếp: Chúng tiết ra enzyme và kháng sinh tự nhiên để tiêu diệt hoặc ức chế sự phát triển của nấm bệnh (Fusarium, Pythium…). Ví dụ, nấm Trichoderma còn có khả năng ký sinh và phá hủy trực tiếp màng tế bào của nấm gây bệnh.
- Tăng cường miễn dịch cây trồng: Các vi sinh vật này kích hoạt hệ thống phòng thủ tự nhiên của cây (ISR – Induced Systemic Resistance), giúp cây khỏe mạnh hơn, từ đó tăng khả năng chống chịu với các loại bệnh tật và sâu bọ.
Việc bổ sung các chế phẩm vi sinh vật đối kháng giúp giảm thiểu đáng kể nhu cầu sử dụng thuốc bảo vệ thực vật hóa học, góp phần tạo nên nền nông nghiệp sạch và bền vững.
4. Vai trò của vi sinh vật đối với đất trồng trong canh tác nông nghiệp

Có thể thấy vi sinh vật là loài vật có số lượng lớn cũng như rất đa dạng. Mật độ phân bố của chúng cũng rất rộng rãi chính vì thế mà chúng có vai trò hết sức quan trọng đối với canh tác nông nghiệp. Cụ thể như sau:
4.1 Cải thiện cấu trúc đất
Vai trò đầu tiên của vi sinh vật mà chúng ta không thể phủ nhận đó chính là cải thiện cấu trúc đất trồng. Điều này sẽ được phát huy hiệu quả cao nhất khi chúng ta bón Cellulose và Protein cho đất vì vi sinh vật đã thực hiện quá trình phân giải xenluloza và protein một cách vô cùng mạnh mẽ.
Các chất này kết hợp với các chất tiết của chúng trong quá trình sống chính là chất keo giúp liên kết các hạt đất trồng lại với nhau. Từ đó giúp cho cấu trúc đất chặt chẽ hơn, tăng độ tơi xốp, giúp rễ cây dễ dàng phát triển và đất thoát nước tốt hơn.
4.2 Chuyển hóa dinh dưỡng
Trong quá trình chúng ta sử dụng phân bón cho cây cho dù là phân vô cơ hay hữu cơ, việc phân có tác dụng nhanh hay chậm đến sự phát triển của cây trồng là nhờ hoàn toàn vào quá trình hoạt động của vi sinh vật.
Vi sinh vật sẽ tiến hành phân giải hữu cơ thành dạng vô cơ để hỗ trợ cho cây trồng hấp thụ một cách dễ dàng hơn. Biến dạng các loại vô cơ khó tiêu thành dễ tiêu. Quá trình này còn được gọi là khoáng hóa chất hữu cơ.
4.3 Sinh tổng hợp dinh dưỡng cho cây trồng
Các loại vi sinh vật sống trong vùng rễ thường sẽ có quan hệ mật thiết với cây trồng của chúng ta. Chúng sẽ sử dụng những chất tiết của cây để quay trở lại làm chất dinh dưỡng nuôi sống cơ thể mình. Đồng thời với đó là cung cấp chất dinh dưỡng cho cây qua quá trình hoạt động và phân giải của mình. Ngoài ra, vi sinh vật còn tiết ra các vitamin cũng như chất sinh trưởng cần thiết đối với sự phát triển của cây trồng.

4.4 Phân giải các chất hữu cơ trong đất
Như đã nói ở trên, nhiệm vụ chính của vi sinh vật đó là phân giải các chất hữu cơ có trong đất như cellulose, lignin,… và các xác bã thực vật, động vật chết. Từ đó, tạo nên các chất khoáng và mùn để bổ sung dinh dưỡng cần thiết cho đất.
Quá trình này giải phóng Carbon dioxide (CO2) và các hợp chất đơn giản trở lại môi trường, tạo thành mùn (humus) – yếu tố then chốt quyết định độ phì nhiêu và khả năng giữ nước của đất. Humus còn giúp ổn định nhiệt độ đất, bảo vệ rễ cây khỏi sự thay đổi nhiệt độ đột ngột.
⫸ Xem thêm: Phân vi sinh vật phân giải chất hữu cơ là gì?
4.5 Tổng hợp acid humic
Hoạt động của các loại vi sinh vật thuộc nhóm hiếu khí giúp hình thành nên một thành phần có trong mùn đó chính là acid humic. Loại acid này sẽ cùng với các acid mùn khác kết hợp lại và giúp kích thích sự phát triển của hệ rễ. Từ đó giúp cho cây có thể hấp thu chất dinh dưỡng tốt hơn. Đây là nguyên nhân chính giúp cho cây sinh trưởng phát triển mạnh hơn.
Trong trường hợp chúng được hấp thu trực tiếp qua lá thì sẽ tăng cường sự quang hợp của cây một cách mạnh mẽ hơn vì các enzyme tham gia trong quá trình quang hợp được tác động một cách trực tiếp. Sống trong môi trường có ánh sáng càng mạnh, cường độ quang hợp cũng mạnh thì dĩ nhiên là cây sẽ sinh trưởng nhanh.
Bên cạnh đóm, Acid humic cũng rất hiệu quả trong việc tăng sức đề kháng của cây. Giúp cây có thể chống lại các loại sâu bệnh một cách tốt hơn. Cho dù là sống trong điều kiện môi trường bất lợi như nóng, rét, hạn, úng, chua phèn cũng đều thích nghi tốt.
⫸ Xem thêm: Humic là gì? Cách sử dụng humic bón cây hiệu quả

4.6 Chuyển hóa các hợp chất khó tan
Vai trò này của vi sinh vật thì hẳn là nhiều người trong chúng ta cũng đã biết rồi phải không nào trong đó đặc biệt phải kể đến Lân. Nhiều dạng Lân trong đất tồn tại ở dạng kết tủa hoặc liên kết với các khoáng chất khác (như Canxi, Sắt) khiến cây không hấp thụ được.
Vi sinh vật phân giải Lân sẽ tiết ra các axit hữu cơ và enzyme để hòa tan những hợp chất khó tan này, chuyển Lân thành dạng ion dễ tiêu, giúp cây tận dụng tối đa lượng phân bón được cung cấp. Khả năng này giúp tăng hiệu suất sử dụng phân lân gấp nhiều lần.
4.7 Giải phóng các chất khoáng
Các vi sinh vật có trong đất với khả năng giải phóng các chất khoáng bị giữ chặt trong đất như lưu huỳnh, sắt, Kali… thành các dạng giúp cho cây hấp thụ một cách dễ dàng hơn. Quá trình này còn bao gồm việc giải phóng các nguyên tố vi lượng (như Zn, Cu) ra khỏi cấu trúc khoáng. Từ đó, đảm bảo cây nhận được đầy đủ các dưỡng chất cần thiết cho quá trình trao đổi chất và sinh trưởng. Đặc biệt, vi khuẩn oxy hóa lưu huỳnh giúp chuyển hóa Lưu huỳnh trong đất thành dạng SO4 mà cây có thể hấp thụ.
4.8 Cố định Nitơ
Một số loài vi sinh vật tồn tại và phát triển trong đất có khả năng cố định nitơ ở bên trong không khí sau đó chuyển hóa đạm thành dạng NH4+ và N03–. Đây là 2 dạng đạm cây rất dễ để hấp thu. Các vi khuẩn cố định Nitơ tự do (như Azotobacter) và cộng sinh (như Rhizobium) đóng vai trò như một nhà máy sản xuất đạm tự nhiên, làm giảm đáng kể nhu cầu bón phân hóa học cho cây trồng. Ước tính, vi sinh vật cố định có thể cung cấp hàng chục đến hàng trăm kg đạm/ha mỗi năm.

Trên đây là những thông tin về vai trò của vi sinh vật trong đất canh tác nông nghiệp mà chúng tôi muốn chia sẻ với bạn qua bài viết ngày. Hãy biết cách tận dụng tối đa lợi thế của hệ vi sinh vật hữu ích trong đất để thúc đẩy cây trồng phát triển và cải tạo đất hiệu quả. Mọi thắc mắc về Vai trò của vi sinh vật đối với đất trồng trong canh tác nông nghiệp xin vui lòng liên hệ tư vẫn miễn phí: 0934.214.579 hoặc truy cập website: chephamvisinh.vn để tìm hiểu kỹ hơn nhé! Xin cảm ơn các bạn đã theo dõi bài viết!
⫸ Xem thêm: Cách làm tăng độ ngọt cho quả an toàn, chất lượng nhất
⫸ Xem thêm: Chế phẩm sinh học EM là gì? Thành phần, Công dụng, Cách sử dụng & cách pha chế chi tiết nhất
Thông tin liên hệ
Công ty TNHH Công nghệ sinh học Đức Bình
MST: 0108433217
Địa chỉ: 57 ngõ 64 Kim Giang, Khương Đình, Hà Nội
SĐT: 024.66.55.46.86
Văn phòng giao dịch
Chế phẩm vi sinh Đức Bình – Trung tâm nghiên cứu và ứng dụng chế phẩm sinh học chuyên nghiên cứu, sản xuất và ứng dụng các dòng sản phẩm: Men vi sinh, men bể phốt, men xử lý nước thải, men thuỷ sản, chế phẩm sinh …
Địa chỉ : 1B Ngõ 774 Kim Giang, Thanh Liệt, Hà Nội
SĐT: 0934.214.579
Hotline: 024.66.55.46.86
Email: chephamvisinhungdung@gmail.com
Website: https://webvisinh-mai.webmanhan.com
